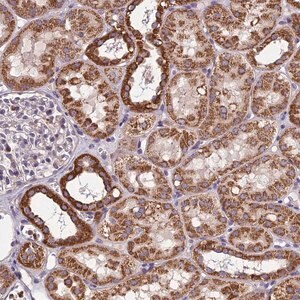
Merck Anti-CTD-3088G3.8 antibody produced in rabbit

Merck Anti-CTD-3088G3.8 antibody produced in rabbit
상품 한눈에 보기
토끼에서 생산된 Anti-CTD-3088G3.8 항체로, 친화력 분리 정제된 항체입니다. 버퍼링된 수성 글리세롤 용액 형태이며, AC099489.1 단백질(Protein LOC388210)을 인식합니다. 연구용 단백질 검출 및 분석에 적합합니다.
브랜드: Merck Sigma
✨AI 추천 연관 상품
AI가 분석한 이 상품과 연관된 추천 상품들을 확인해보세요
연관 상품을 찾고 있습니다...
Anti-CTD-3088G3.8 antibody produced in rabbit
제품 개요
- 친화력 분리 정제된 항체 (affinity isolated antibody)
- 버퍼링된 수성 글리세롤 용액 (buffered aqueous glycerol solution)
- 토끼에서 생산 (produced in rabbit)
항원 정보
- Target: Anti-AC099489.1
- Protein: LOC388210
- Reference: ECO:0000313 | Ensembl: ENSP00000471908
제품 사양
| 항목 | 내용 |
|---|---|
| 제품명 | Anti-CTD-3088G3.8 antibody |
| 생산 동물 | Rabbit |
| 정제 방식 | Affinity isolated |
| 형태 | Buffered aqueous glycerol solution |
| 타겟 단백질 | AC099489.1 (Protein LOC388210) |
| 데이터베이스 참조 | ECO:0000313, Ensembl: ENSP00000471908 |
🏷️Merck Sigma 상품 둘러보기
동일 브랜드의 다른 상품들을 확인해보세요

Merck Sigma
Merck Anti-QSOX1 antibody produced in rabbit
895,700원

Merck Sigma
Merck Anti-ADAMTS13 antibody produced in rabbit
370,530원
Merck Sigma
Merck Anti-CTD-3088G3.8 antibody produced in rabbit
370,530원

Merck Sigma
Merck Anti-MC5R antibody produced in rabbit
895,700원

Merck Sigma
Merck Anti-SLC25A15 antibody produced in rabbit
895,700원
배송/결제/교환/반품 안내
배송 정보
| 기본 배송비 |
| 교환/반품 배송비 |
|
|---|---|---|---|
| 착불 배송비 |
| ||
| 교환/반품 배송비 |
| ||
결제 및 환불 안내
| 결제수단 |
|
|---|---|
| 취소 |
|
| 반품 |
|
| 환급 |
|
교환 및 반품 접수
| 교환 및 반품 접수 기한 |
|
|---|---|
| 교환 및 반품 접수가 가능한 경우 |
|
| 교환 및 반품 접수가 불가능한 경우 |
|
교환 및 반품 신청
| 교환 절차 |
|
|---|---|
| 반품 절차 |
|
문의 0
로그인 후 문의를 할 수 있습니다.